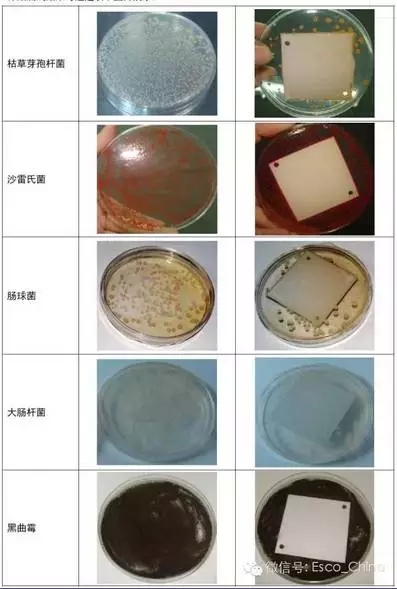

| 添加日期:2015年07月29日 | 关键字: | 点击次数:1317 次 |
Esco公司专注于实验室洁净技术,对于洁净产品而言,有效地抑制产品表面微生物的滋生显得尤为重要。
Esco全系列产品表面均采用IsocideTM抗菌涂层技术。IscocideTM抑菌材料主要成份含有银离子,具有长期抑菌作用,且不会因为表面清洗而被消除,可在24-48小时内消除柜体表面99.9%的滋生细菌。

以下测试程序,基于JIS和ASTM的标准,提供了关于IsocideTM抗菌涂层的测试数据。
一、首先进行微生物制备:
适用于这次实验的细菌包括枯草芽孢杆菌,沙雷氏菌,链球菌,肠球菌,埃希式杆菌,葡萄球菌。常用的酵母培养物是啤酒酵母,假丝酵母。细菌和酵母培养物的制备需要通过2个阶段,他们的营养细胞的制备是在PH7.3的磷酸盐缓冲溶液中24小时用于细菌的生长繁殖,36个小时用于酵母培养物的生长。枯草芽孢杆菌和黑曲霉孢子溶液也会应用在这次试验中,浓度分别为1.5*1010/ml和5*108/ml。
二、其次进行实验并采集数据:
1. 测试板采用50*50mm的镀锌钢板,表面喷涂Isocide粉末,然后在180度下高温烘焙,再用70%的异丙醇溶剂擦拭,在20度以下保存。
2. 所有的测试微生物用移液器吸取到0.1ml的琼脂板上,使其蔓延到整个琼脂表面,测试板放置到接种过的琼脂板中间,细菌培养传播到胰蛋白酶琼脂,酵母培养液接种到葡萄糖琼脂,霉菌传播到马铃薯葡萄糖琼脂表面
3. 24-48小时后观察细菌的生长情况,48-72小时观察酵母的情况,霉菌的观察需要等到1周的发酵周期结束。所有的生长情况用文本记录。
三、结果:
|
微生物 |
生长情况 |
|
|
测试板 |
测试板外 |
|
|
枯草芽孢杆菌 |
+ |
+++ |
|
沙雷氏菌 |
- |
+++ |
|
葡萄球菌 |
- |
+++ |
|
链球菌 |
- |
+++ |
|
肠球菌 |
- |
+++ |
|
大肠杆菌 |
- |
+++ |
|
啤酒酵母 |
- |
+++ |
|
假丝酵母 |
- |
+++ |
|
黑曲霉 |
- |
+++ |
暴露区域:(-)无生长,(+)部分生长
控制区域:(+++)全部生长
详细测试结果可以通过以下图片展示:
信息来源:ESCO
由此可见,Esco独有的IsocideTM抗菌涂层可在24-48小时内有效抑制柜体表面微生物的滋生,防止交叉污染,为保护您的宝贵实验样品免受污染提供了更多一层的保障。
详情请咨询南京庚辰科学仪器有限公司,关于A2型二级生物安全柜,AC2-S系列。
